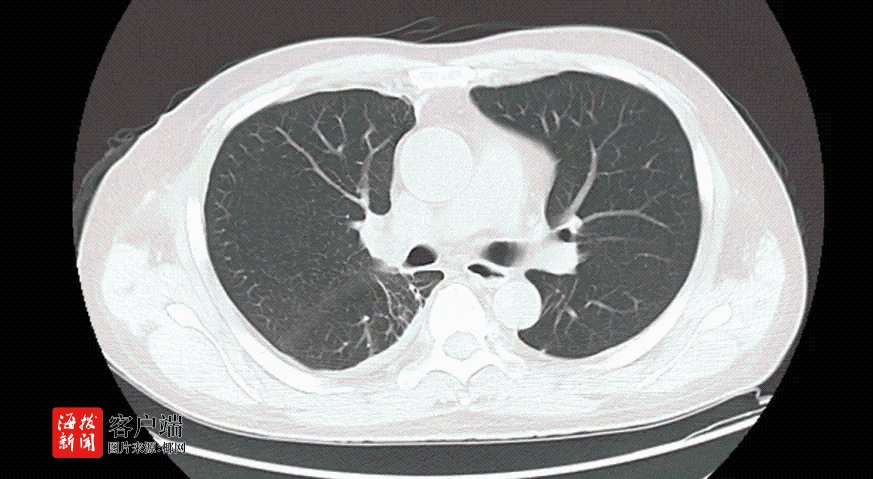

一男子胸腔大出血命悬一线,海医一附院紧急出手救回一命

一男子胸腔大出血命悬一线,海医一附院紧急出手救回一命

一男子胸腔大出血命悬一线,海医一附院紧急出手救回一命
商报全媒体讯(椰网/海拔新闻记者 孙鑫 通讯员 刘清峰 刘运仲 赵宏光)近日,海南医科大学第一附属医院胸外科上演了一场惊心动魄的“生死时速”。一位50岁的卢先生,因车祸导致的胸部闭合性损伤并发血胸,命悬一线。幸运的是,在医护团队的共同努力下,他最终化险为夷,重获新生。

胸腔大出血是胸部外伤的常见并发症之一,胸壁闭合性损伤并发胸腔出血多由肋骨骨折导致,而无肋骨骨折的胸部闭合性损伤往往更容易被忽视,一旦出现大出血,那将是致命的危险。
据了解,卢先生因车祸被120紧急送入该院救治。入院时,医护人员迅速检查发现,他不仅右侧液气胸(少量)、创伤性湿肺、椎体压缩性骨折,还出现了面色苍白、心率加快、血压下降,血色素急剧下降等症状。胸部CT检查更是显示,他的右侧胸腔大量积血,肺压缩高达80%,右胸腔大片高密度影较前增大,生命岌岌可危。
面对如此危急的病情,医护人员在急诊床旁为卢先生行右侧胸腔闭式引流术,胸腔引流管引出大量暗红色血性液体。该院胸外科副主任刘运仲也迅速赶到现场会诊。他凭借丰富的急救经验,果断判断卢先生胸外伤未合并肋骨骨折,但有大量气胸,肺部破裂,右胸腔大片高密度影及胸腔引流出的大量血性液体均提示有胸腔大出血的情况,但大出血原因不明。考虑到卢先生发病突然,且疾病进展快,凶险程度高,时间紧迫,他立即向胸外科主任赵宏光汇报,并准备进行手术探查止血。
为了保障卢先生的生命安全,该医院迅速开通绿色通道,急诊和创伤外科、胸外科、麻醉科、血库等多个科室通力合作,上演了一场生死时速的接力赛。
经过快速准备,胸外科团队刘运仲主任医师、刘清峰医师等人对卢先生进行了单孔胸腔镜手术探查。术中探查发现,卢先生整个胸腔有大量血凝块及积血。在快速清除胸腔积血及血凝块后,终于找到了出血点——卢先生右肺上叶与胸膜粘连处明显有肺破裂出血,创面大。他们迅速采用直线切割闭合器楔形切除出血肺组织,并进行了充分的止血处理。经历1个多小时的手术,终于将卢先生从死亡线上拉了回来。
“卢先生出血总量达3300ml,人体血量通常占体重的7%~8%。估算患者血量约为4900ml至5600ml,相当于失去了2/3的血量。”手术结束后,刘清峰医师感叹道,正是医护团队及时准确的判断、各科室通力合作和迅速有效的救治,才使卢先生得以转危为安。术后,经过医护团队的精心照护,卢先生病情逐渐平稳。
如今,卢先生已经康复出院。出院时,他和家人对海南医科大学第一附属医院医护团队及时、专业的救治表示衷心的感谢。生命高于一切,看着患者脱离危险,海医一附院的人心里无比高兴。这场生死时速的较量,不仅彰显了医护人员的专业素养和团队精神,更体现了对生命的尊重和敬畏。
【责任编辑:黄奕宏】
【内容审核:杨颜应】
版权声明:国际旅游岛商报全媒体文字、图片、视频、音频等版权作品,欢迎转发,但非经本报书面授权同意,严禁包括但不限于转载或改编、引用等,违者必追究法律责任。